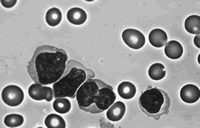
�����ƻ�����ALL�����׷���

经治疗缓解后的ALL患儿易发胖
|
既往有报告指出,经治疗缓解并生存的急性淋巴细胞白血病(ALL)患儿的机体构成通常会发生变化,但ALL及其治疗对经治疗缓解后的患儿机体构成的影响尚未被充分验证。澳大利亚昆士兰大学的Murphy医师等最近的一项横断面研究表明,经治疗缓解的ALL患儿容易发胖。
这项研究测定了24例经治疗缓解的ALL患儿和24例年龄与患儿相匹配的健康对照组儿童的身高、体重、体积、机体总含水量和骨矿物质含量。Murphy医师等用四分量模型评估了两组儿童的机体组分和非脂肪组分(FFM)。
结果表明,与年龄匹配的对照组儿童相比,ALL缓解后生存患儿的平均体质指数和肥胖指数均显著增高(两项指标的P值均为0.05)。检测FFM后可知,与对照组儿童相比,经治疗缓解的ALL患儿机体含水量较高(P=0.001),而密度较低(P=0.0001)。(Am J Clin Nutr 2006, 83:70)
研究提示:经治疗缓解后的ALL患儿容易发生肥胖。应进行更大规模的研究,精确测量ALL患儿群体的机体构成变化,并分析这个患儿群体的FFM表现为高含水量和低密度的原因。, http://www.100md.com